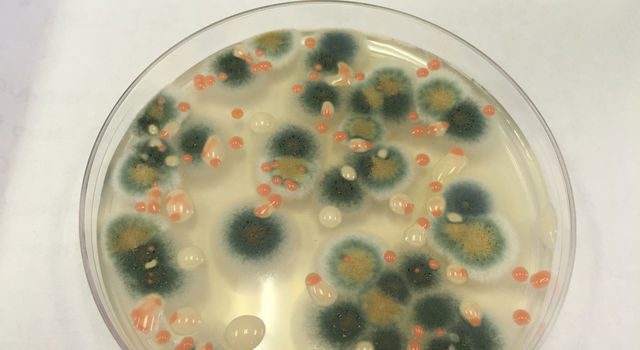
Едят ли микробы космические станции - 7
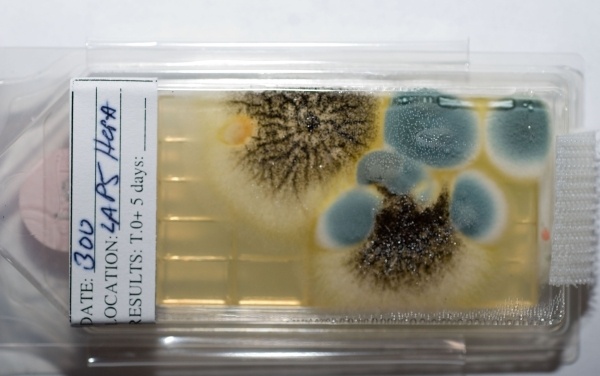
Едят ли микробы космические станции - 8

У людей есть самые разные представления о количестве и опасности микрофлоры на космических станциях. Кто-то считает, что там стерильная чистота, а кто-то верит в жуткие истории о грибках, которые чуть не съели станцию «Мир» и микроорганизмах-мутантах, заражавших космонавтов. Реальность, конечно же, находится между этими крайностями, но к какому полюсу она ближе?
Как на «Мире» вырос червяк
Достаточно известен миф о том, что станция «Мир» была затоплена якобы из-за какого-то жуткого микроба, грибка или вируса, который всюду расплодился и стал поедать корпус станции и прилетавших на нее космонавтов. У этого мифа нет четкой формы, поэтому, если вы попытаетесь его найти в поисковиках, то можете увидеть разные варианты — где-то пишут про «водоросли», которые росли на всех поверхностях, где-то — про то, как некая зараза поражала космонавтов. Передача «Военная тайна» РЕН-ТВ сделала эту историю довольно хорошо известной.
Отсутствие серьезных источников и явное фричество сайтов, где упоминается эта история (на одном из таких сайтов, например, рекламируется средство от грибка, а история про «Мир» добавлена для SEO) явно говорит о том, что это выдумка. Но в то же время часто упоминается история с космонавтом Серебровым, который не то нашел червяка в трубке станции «Мир», не то заразился каким-то страшным мутантом. И в видео выше на 3:20 Серебров сам рассказывает историю о том, как нашел полутораметрового червяка в трубке системы регенерации воды. В другом видео Гречко рассказывает про «змею», а Серебров — про «червяка» (с 24:30):
Но если послушать дальше, то все-таки Серебров говорит, что это был не живой червяк, а «биологический материал». Ищем дальше. У украинской «Комсомольской правды», очевидно, трубка диаметром 8 миллиметров, сделала полутораметрового червяка восьмиметровым, а Серебров оказался заражен неким космическим мутантом. В еще одном видео Серебров рассказывает о том, что это была «плесень, зеленая» и «биологический материал» (с 5:23).
Дальше уже начинаются журналистские фантазии про неизвестное происхождение, высокую проникающую способность, неуничтожимость и бессмертие этого «червяка», отсутствие у людей иммунитета к нему и поражение станции «Мир» этим «штаммом „Андромеда“». В интервью Сереброва «Новой газете» «червяк» превращается в «дрожжевую бактерию».
По этим материалам картина становится более-менее ясной. Получается, что источником этого ужастика является сам Серебров. В некоторых интервью он недостаточно ясно говорил, что «червяк» был не живым, а скоплением неких микроорганизмов, а некоторые недобросовестные журналисты раздули эту неясность в жуткую неубиваемую заразу. Что же касается болезни Сереброва — то тут наиболее правдоподобным видится вариант, когда он от этой гадости действительно мог заполучить недомогание или диарею, но, очевидно, сумел выздороветь. В противном случае он вряд ли бы прожил двадцать лет после полета и не смог бы спокойно давать интервью, находясь в карантине.
А что же в реальности?
Наверное, самым авторитетным специалистом по космическим микробам является Наталья Дмитриевна Новикова, доктор биологических наук, действительный член Международной академии астронавтики, заведующая лабораторией Государственного научного центра РФ — Института медико-биологических проблем РАН «Микробиология среды обитания и противомикробная защита». Проект «ПостНаука» взял у нее интервью, и, бинго! — мы видим эту же историю Сереброва, но уже в адекватном изложении (на 8:54).
И если посмотреть видео целиком (что я очень рекомендую), то открываются новые интересные истории. Оказывается, микрофлора на «Салюте-7», «Мире» и МКС присутствует и активно пытается поедать все, что может. Там, где создаются подходящие условия, высокая влажность и питательные вещества, бактерии и грибы начинают поедать пластиковую изоляцию, расти на стекле и повреждать его выделяемыми при росте кислотами.
В 2015 году в условиях избыточной влажности в установке Veggie, выращивающей цинии, появилась плесень.

В условиях постоянной борьбы то с повышенной, то с пониженной влажностью, Скотту Келли, пусть и потеряв два цветка, все-таки удалось добиться цветения оставшихся.
Также на МКС однажды обнаружили плесень в месте сушки одежды после спортивных упражнений, которыми космонавтам приходится заниматься по два часа каждый день.

На станции «Мир» под редко открываемой панелью однажды нашли шар грязной воды размером с баскетбольный мяч (если бы источником не было бы NASA, было бы труднее поверить) в котором прекрасно себя чувствовали не только бактерии, но и амебы с простейшими.



С поверхностей МКС регулярно берут мазки, которые показывают разнообразие обитающей там микрофлоры:

Для облегчения задач определения, «кто тут живет» даже разрабатываются специальные устройства. Вот этот вот «нос» разработки Airbus должен ловить на анализ микробы лучше, чем знакомые нам ватки и чашки Петри с питательной средой.

И уборка на МКС обязательно включает в себя мероприятия по дезинфекции. Кроме стандартного протирания поверхностей дезинфицирующими жидкостями воздух дополнительно очищает система «Поток», где микробов изводят электричеством.

Недостижимая стерильность
А можно ли сделать МКС стерильной? Для ответа на этот вопрос надо понять две вещи — как микробы попадают на МКС и как производится дезинфекция. С первой частью все печально — множество микробов живет на самом человеке, и вывести их полностью никак невозможно. Также, грузовые корабли, пусть их и дезинфицируют, прилетают чистыми, но не стерильными, и с каждым новым грузовиком на МКС может с небольшой вероятностью прилететь что-нибудь новое. Ответ на вторую часть тоже не радует — методы стерилизации в виде кипячения под давлением, радиационной и химической обработки несовместимы с живыми космонавтами. Поэтому экипажи МКС и последующих кораблей и станций все так же будут бороться с бактериями и плесенью, и гибель от нее растений будет реальной опасностью и для лунной базы, и для марсианского корабля.
Жизнь везде
Благодаря МКС мы знаем, что жизнь настолько живуча, что ее следы можно обнаружить даже на внешней поверхности станции. Прежде всего, самими людьми проводятся эксперименты по экспозиции (выдерживанию) в условиях космоса бактерий, грибков, семян, яиц и личинок животных. У нас это эксперимент «Биориск», в Европейском Космическом агентстве — Expose

Эксперимент Expose на внешней поверхности МКС
Кроме этого удивительные данные были получены сравнительно недавно. В 2014 году на внешней поверхности МКС были обнаружены следы планктона. Очевидно, наша Земля, двигаясь по орбите, рассыпает поднявшуюся случайно вверх жизнь во все стороны. Так что, если на Марсе вдруг найдут бактерии, они вполне могут оказаться потомками случайно поднятых мощной грозой земных бактерий или потомками тех, кто прилетел вместе с чистыми, но не абсолютно стерильными аппаратами.
Благодарности за статью прошу высылать maedv — он прислал мне шикарную подборку материалов по «червяку» Сереброва.
Автор: lozga
